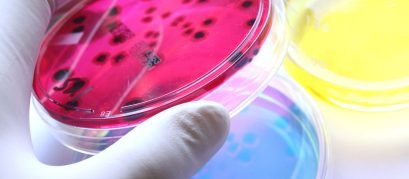
Ágar Cromogênico
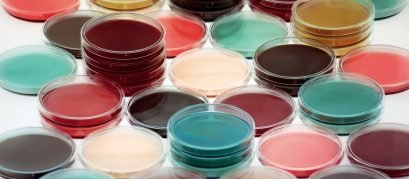
TSA Meio de Cultura
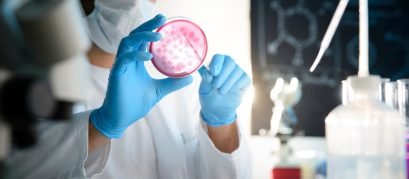
Caldo Tioglicolato

Nosso Blog
Blog da SP Labor
Dicas e Novidades - Sua Fonte de Conhecimento em Equipamentos e Tecnologia para Laboratório.
Meio de Cultura
Categorias
5 abr 2026
Guia Técnico de Incubação e Conformidade RDC Você preparou o meio de cultura perfeitamente. Mas colocou em estufa sem temperatura controlada. Resultado? Contaminação. Crescimento irregular....
11 jul 2025
Guia de Uso: Como preparar meios de cultura com balança analítica e agitador magnético No cenário microbiológico, a qualidade dos resultados obtidos em testes depende...
26 maio 2025
Microbiologia preditiva: como antecipar riscos microbiológicos nos alimentos? A microbiologia de alimentos é uma ciência vital para garantir a segurança, qualidade e durabilidade dos produtos...
13 mar 2025
O que é Triptona? Saiba a sua Importância para a Microbiologia. O ágar triptona vem sendo usado com sucesso por décadas para desenvolver e manter...
23 ago 2024
Validação dos Meios de Cultura: Garantindo Resultados Precisos em Experimentos Científicos A validação dos meios de cultura é um passo fundamental para assegurar a...
2 ago 2024
Evitando Armadilhas na Preparação de Meios de Cultura: Os 10 Erros Mais Comuns Em um laboratório de microbiologia, os meios de cultura são a...
10 jun 2024
O que é Extrato de Levedura? Qual a sua função e importância para a microbiologia? O extrato de levedura é fundamental para a microbiologia, sendo...
9 mar 2024
Vamos entender como age o Ágar Hektoen? Qual a sua função, preparação e Guia de Compras O ágar Hektoen entérico (HE) é um meio de...
8 mar 2024
Vamos entender o Ágar Hecktoen? O que é esse Meio de Cultura? O meio de cultura é de fundamental importância para a maioria dos testes...
8 mar 2024
O que é Peptona ? Qual sua importância para Microbiologia? Se você é estudante ou profissional da área de microbiologia, com certeza já ouviu falar...
7 mar 2024
O que é Ágar Bacteriológico? Entendendo sua Importância na Microbiologia O ágar bacteriológico é essencial nos laboratórios de microbiologia para o cultivo e identificação de...
9 fev 2024
O que é Cultura Celular? Entenda mais sobre essa técnica. A cultura celular é uma ferramenta muito versátil na investigação de questões...
30 jan 2024
O que é Ágar Mac Conkey? Qual a sua função? E a sua Importância? O ágar MacConkey é um dos meios de cultura para microbiologia ...
20 jan 2024
O que é Ágar Batata Dextrose? Qual a Importância desse Meio de Cultura? Bem-vindo ao guia completo sobre o Ágar Batata dextrose! Se você...
17 jan 2024
O que é o Ágar Cled? Qual a sua função? Bem-vindo ao mundo da microbiologia! Você já ouviu falar sobre o ágar...
8 jan 2024
Você conhece o Ágar Chocolate? Qual a importância desse meio de cultura? A microbiologia, a ciência que estuda os micro-organismos, depende de meios de cultura...
15 dez 2023
Descobrindo o Teste do Lisado de Amebócito de Limulus (LAL): Uma Ferramenta Crucial na Detecção de Endotoxinas Endotoxinas são substâncias tóxicas associadas à membrana externa...
16 nov 2023
Guia Completo Sobre Meio de Cultura para Fungos: Importância e Aplicações No mundo da microbiologia, o meio de cultura para fungos desempenha...
9 nov 2023
O que é Ágar Sabourand Dextrose? Qual a sua função? Preparação e Importância. Muitas vezes nos deparamos com expressões em laboratórios que nem sempre nos...
31 out 2023
Meios de Cultura Himedia: Agregando Valor ao seu Laboratório Quando se trata de realizar pesquisas científicas de alta qualidade, a escolha dos meios de cultura...
19 set 2023
Guia Completo: Como Escolher o Material de Laboratório Certo para Cultura de Células Você sabia que a escolha adequada do material de...
16 ago 2023
Análise Microbiológica em Produtos Lácteos: Uma Visão Aprofundada Os produtos lácteos são um dos alimentos mais consumidos no mundo, e a sua qualidade microbiológica...
10 jul 2023
O que é o Extrato de Malte? Sua função na Microbiologia? Bem-vindo(a) ao fascinante mundo da microbiologia! Você já parou para pensar como os...
5 jun 2023
O que é o Caldo TSB? Se você é estudante ou profissional da área de microbiologia, provavelmente já ouviu falar do caldo TSB....
27 mar 2023
O que é água peptonada tamponada em microbiologia Você já ouviu falar em água peptonada tamponada? Essa solução é amplamente utilizada na microbiologia como meio...
17 mar 2023
O que é o Ágar eosina azul de metileno “Se você é um entusiasta da microbiologia, provavelmente já ouviu falar do ágar eosina azul...
13 mar 2023
O que é o Caldo nutriente? Sua Importância para a Microbiologia Você já ouviu falar em caldo nutriente? Se você está estudando...
10 mar 2023
Ágar Cetrimide e a sua Importância para a Microbiologia? Se você é um amante da microbiologia, certamente já ouviu falar do Ágar Cetrimide. Essa substância...
10 mar 2023
TSA – Meio de Cultura Importante Se você é um iniciante no mundo da microbiologia, pode ser uma tarefa assustadora escolher o meio de cultura...
9 mar 2023
O que é Ágar Cromogênico ? Função? Importância? Se você está interessado em microbiologia, provavelmente já ouviu falar sobre Ágar Cromogênico. Este meio de...
8 mar 2023
O que é o Caldo Tioglicolato? Qual a sua função e a Importância para a Microbiologia? Você sabia que o Caldo Tioglicolato é um...
7 mar 2023
O que é o meio de cultura para microbiologia- Meio Luria Bertani- Função, Composição e Princípios Você sabia que o meio de cultura é um...
3 mar 2023
O que é Ágar Baird Parker O Ágar Bair Parker é um tipo de substrato usado na microbiologia para o crescimento de bactérias. Ele é feito...